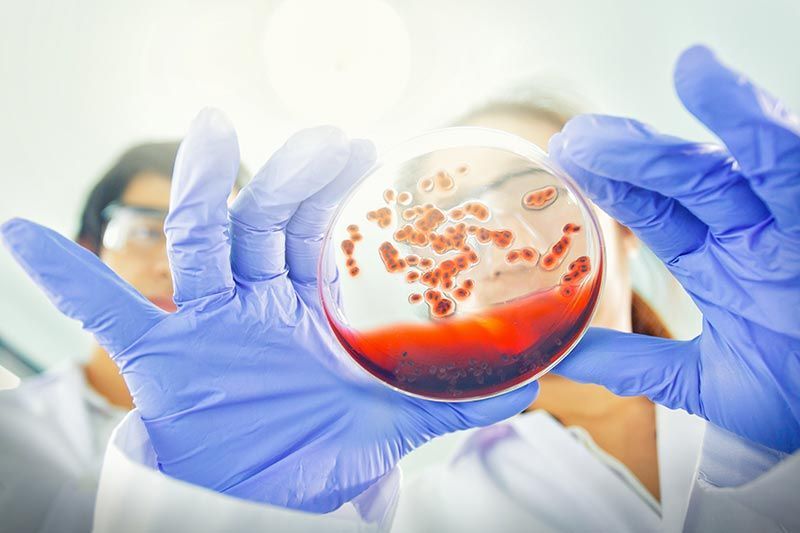
LABORATORIO SANTA FE

Laboratorio Santa Fe: precisión y confianza en cada resultado desde el 2010
Somos el laboratorio clínico en Oaxaca de confianza para miles de pacientes.
Ubicados en el centro de la ciudad de Oaxaca de Juárez, nos especializamos en la realización de estudios y análisis clínicos con la más alta precisión.
Cada resultado que entregamos refleja nuestro compromiso con la salud, ética y excelencia médica.
Te ofrecemos
beneficios
únicos:
Entrega de resultados en hasta dos horas
Si te urgen unos análisis, ofrecemos el gran beneficio de entregar tus resultados en hasta dos horas para aquellos casos que lo permiten. Si solicitas tus estudios dentro del horario laborable, la entrega urgente no tiene costo adicional.
Consulta de resultados vía WhatsApp, mail o en nuestras instalaciones
Puedes recibirlos de forma simple en tu celular o bien, acudir por la versión impresa a nuestra ubicación.
Toma de muestras a domicilio
¿Tu familiar no se puede trasladar a nuestras instalaciones? Nosotros acudimos a hacer la toma de muestras en Oaxaca de Juárez y municipios conurbados. Consulta nuestra cobertura al agendar.
Químicos certificados
Nuestro laboratorio clínico en Oaxaca está compuesto por químicos certificados en la toma de muestras y ante la Federación Nacional de Químicos Clínicos N° SEP/DGP/CP067/14 con número de registro 0151.
Resultados verdaderamente confiables
Cada estudio se realiza con tecnología de vanguardia. Además, para garantizar su exactitud, estamos inscritos a un control de calidad externo que lo ratifica.
CATÁLOGO DE ANÁLISIS CLÍNICOS DE LABORATORIO SANTA FE
Química clínica: mide lo invisible
En nuestro laboratorio clínico en Oaxaca, realizamos estudios de química clínica para evaluar el funcionamiento de órganos vitales.
Análisis sanguíneos: descubre lo que tu sangre dice
Ofrecemos pruebas que analizan los componentes de la sangre para diagnosticar infecciones, anemias y más.
Perfiles hormonales: tu equilibrio bajo la lupa
Evalúa los niveles hormonales del organismo para detectar desequilibrios que afectan funciones metabólicas, reproductivas y endocrinas.
Control y seguimiento en diabetes: aliados en tu monitoreo
En nuestro laboratorio clínico en Oaxaca realizamos estudios para el diagnóstico y monitoreo continuo de pacientes con diabetes.
Cultivos bacteriológicos: identifica con precisión
Detectamos infecciones mediante cultivos que revelan bacterias por PCR multiplex en tiempo real con la plataforma de FilmArray y GeneXpert. Por otro lado, estudiamos la sensibilidad a los antibióticos con el método MIC (Concentración Mínima Inhibitoria).
Inmunología: tu defensa bajo análisis
Realizamos estudios que detectan anticuerpos y otras sustancias que permiten diagnosticar enfermedades autoinmunes o infecciosas bajo un método de alta precisión.
Hematología: la ciencia de tu sangre
En Laboratorio Santa Fe, laboratorio clínico en Oaxaca, estudiamos tus células sanguíneas para identificar trastornos hematológicos con certeza.
Infectología: detectar para actuar
Realizamos diferentes análisis clínicos para diagnosticar virus y bacterias que afectan tu salud de forma silenciosa.
Marcadores tumorales: prevención con anticipación
Analizamos biomarcadores relacionados con ciertos tipos de cáncer, facilitando una detección temprana o el seguimiento de tratamientos oncológicos.
Vectores: un paso adelante ante enfermedades transmitidas
Nuestro laboratorio clínico en Oaxaca realiza pruebas para detectar enfermedades transmitidas por vectores como dengue, zika, Chikungunya, malaria (paludismo), enfermedad de Chagas, entre otras más.
Parasitología: conoce lo que no ves
Estudios parasitológicos que identifican infecciones intestinales u otras condiciones relacionadas con parásitos en el sistema digestivo o general.
Destacamos en el análisis coprológico, mismo que estudiamos de manera más exhaustiva y completa. Realizamos pruebas adicionales como la detección de antígenos bacterianos y virales como salmonella, clostridioides, adenovirus y rotavirus, por el mismo costo.
Biología molecular: tecnología al servicio de la salud
Destacamos como un laboratorio clínico en Oaxaca que ofrece pruebas para la detección de patógenos causantes de ETS mediante ADN y ARN a través metodologías como PCR en tiempo real, PCR punto final, hibridación, entre otras.
En Laboratorio Santa Fe estamos comprometidos con tu salud en cada etapa de tu vida. Si buscas un laboratorio clínico que combine experiencia, atención personalizada y tecnología confiable, somos tu mejor opción.
Agenda tu estudio hoy mismo y comprueba por qué miles de pacientes nos prefieren por la precisión de nuestros resultados y la calidez de nuestro servicio. Tu diagnóstico empieza aquí.
Comunícate con nosotros
Horario de Trabajo
- Lun - Sáb
- -
- Domingo
- -